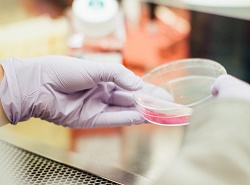

(icono) No Borrar
NOTICIAS GENERALES |
 Imprimir
Imprimir
La equidad de género en las carreras tecnológicas del país se alcanzaría recién en el año 2263Chile tiene uno de los índices más bajo de América Latina en cuanto a la participación de las mujeres en ciencia y tecnología. De hecho, según cifras de la Unesco, las mujeres solo llegan a un tercio del total de participación (32%).
Según estimaciones realizadas por Karin Saavedra, académica de la U. de Talca, doctora en Ingeniería Mecánica y primera ingeniera Aeroespacial del país, la equidad de género en carreras tecnológicas se alcanzaría recién en 244 años más. “La matrícula total femenina de pregrado del Sistema de Educación Superior chileno en el área tecnológica ha aumentado de un 19,4% en el año 2009 a un 20,6% el año pasado. Es decir, en los últimos 10 años. Si se mantiene la misma tasa de crecimiento, se alcanzaría una participación paritaria de género recién en el año 2263. La tecnología es el área de conocimiento con mayor porcentaje de estudiantes y con la menor participación de mujeres – cinco de cada diez hombres se inclinan por esta área, mientras que sólo una de cada diez mujeres tiene esa preferencia”, dice la doctora en Ingeniería Mecánica y también miembro de la Red de Investigadoras. Karen Castillo Investigadora del Centro Interdisciplinario de Neurociencia, de la U. de Valparaíso (Cinv) e integrante de la Academia Mundial de Ciencias (TWAS), dice que en Chile, existe una clara inequidad de género en el contexto de la ciencia, especialmente, en posiciones académicas y directivas. “Los principales obstáculos que enfrentan las mujeres en sus carreras son, por un lado, la discriminación basada en estereotipos, tanto entre sus pares masculinos como femeninos, las dificultades en el ascenso a las jerarquías académicas, la carga académica, el pago equitativo por las mismas labores realizadas, así como la falta de corresponsabilidad en los quehaceres de la vida cotidiana incluyendo desde labores domésticas hasta la crianza de las hijas e hijos”, dice. A juicio de Saavedra, los estereotipos de género temprano son parte de la explicación.“Niñas que juegan a juegos de cocina mientras los niños están dedicados a juegos de lógica con los legos, es parte esta idea temprana que tienen y que va haciendo que al final las niñas no se sientan segura de sus competencias matemática. Tampoco hay un referente femenino, no se ven representada en estas áreas”, indica. ¿Qué hacer? Según Castillo es necesario realizar cambios estructurales, establecer cuotas de participación que garantice la participación de mujeres en la academia, en puestos de decisión de áreas científicas y tecnológicas, crear becas y concursos solo para mujeres. Saavedra también es de la idea de “apurar el paso” para disminuir esta brecha. “En el colegio, los profesores podrían tener una capacitación con enfoque de género para motivar a sus alumnas a que estudien matemática, por ejemplo”. Un reciente estudio de la U. de Talca revisó el rendimiento de los últimos 10 años de sus alumnas. “Nos dimos cuenta que las mujeres ingresaron a la universidad con una brecha de 30 puntos más que los nombres en el NEM, pero en la PSU de matemáticas tenían 10 puntos menos. Sin embargo, a pesar de esa diferencia, tienen mejores resultados en la universidad y la tasa de titulación oportuna también era favorable a las mujeres. Entonces, la pregunta es: ¿Estamos midiendo bien en las pruebas de ingreso a la universidad? Es probable que se deba cambiar la forma y dar más valor a otros índices y no sólo a la PSU”, indica Saavedra.
Vía La Tercera. |